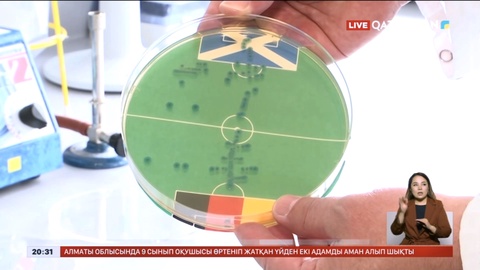

EURO 2024 бойынша жаңалықтар
#EURO 2024
Фильтрді тазалау

Еуропа чемпионатына бір апта қалды
07.06.2024, 20:54

Еуро – 2024: Доп додасынан не күтеміз?
07.06.2024, 18:00
EURO 2024: Германия 3 млн-ға жуық турист қабылдайды
06.06.2024, 20:08
EURO 2024: Германия Шотландияны жеңеді - болжам
05.06.2024, 20:35
14 маусым Еуропа чемпионаты басталады
05.06.2024, 16:44
EURO 2024: Дүбірлі доданың басталуына 9 күн қалды
05.06.2024, 13:00
EURO-2024: «Qazaqstan» мен «Qazsport» телеарналары көрсетеді
04.06.2024, 15:00